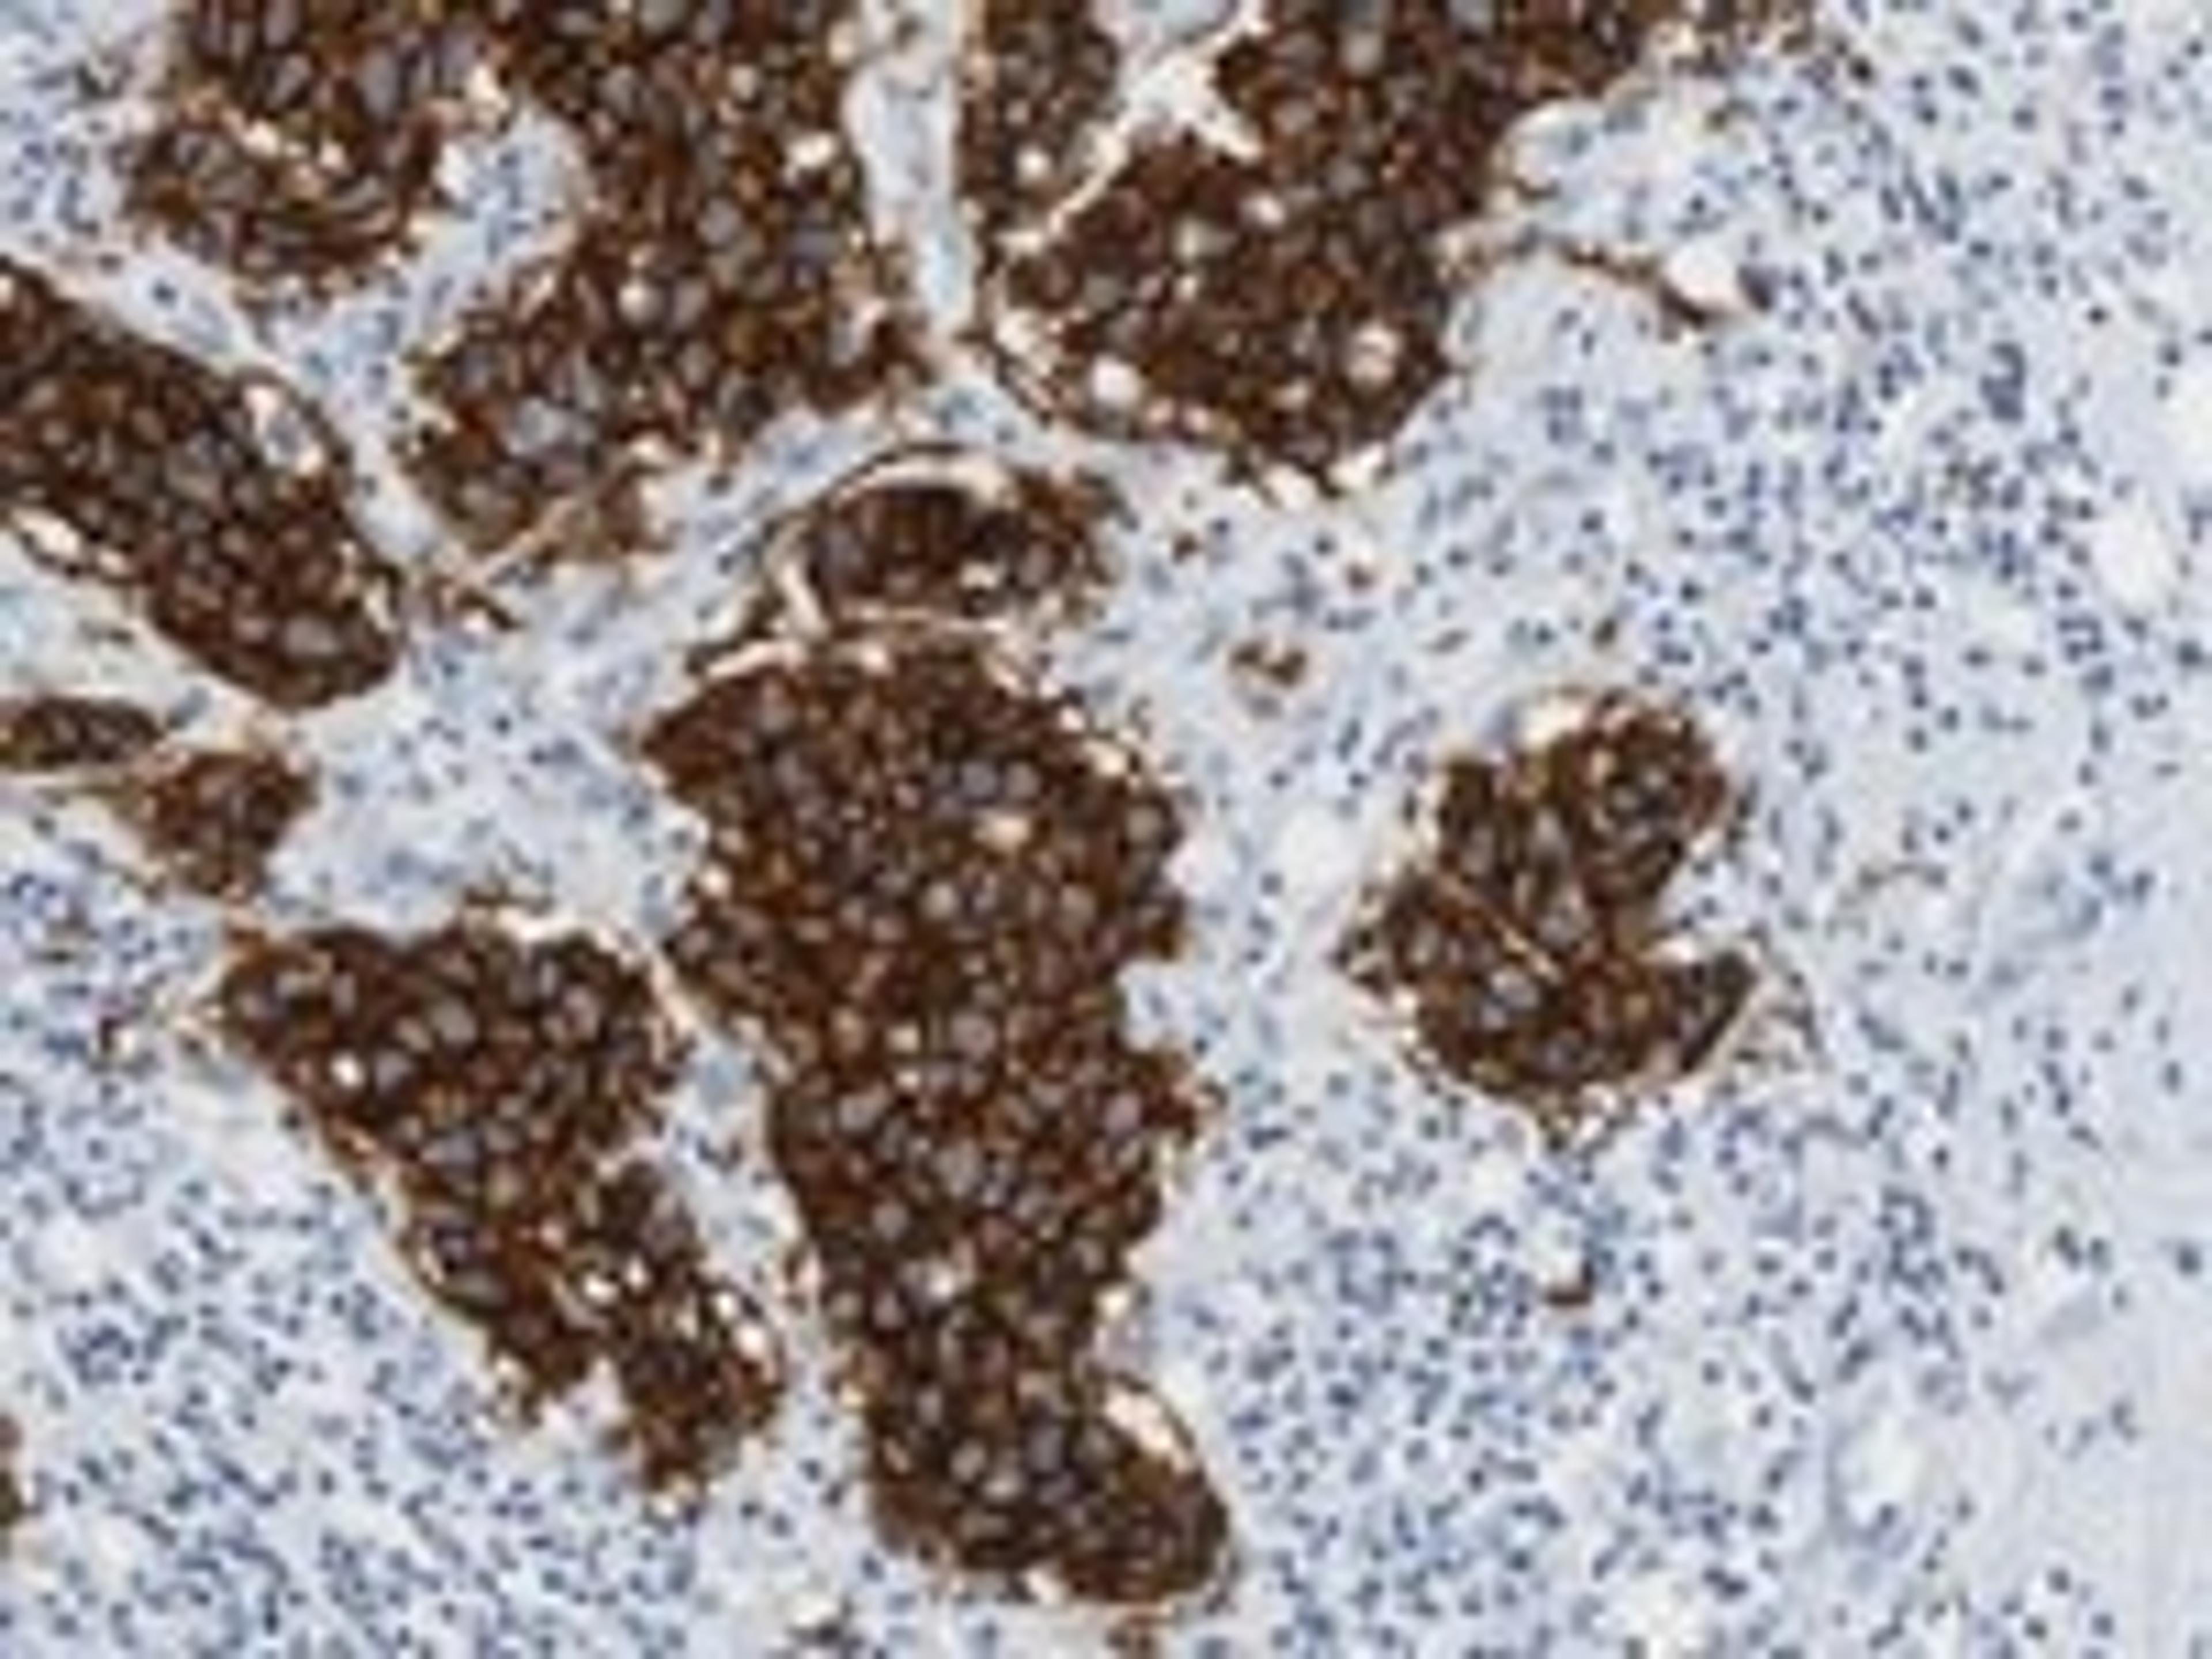

News & Articles
25
Selected Filters:
Industry News
SelectScience Webinar Testimonial
Industry News
SLAS2014: Spotlight on Phenotypic Drug Discovery
Product News
PerkinElmer to Exhibit at Isranalytica 2014
Product News
Opportunities for Growth at ASCB
Industry News